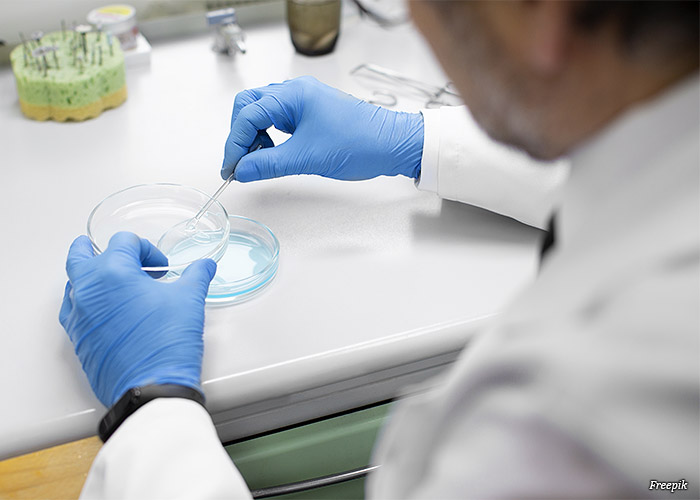

Segurança jurídica, simetria regulatória e diálogo
A posição da Abratec sobre a regulação dos serviços portuários e a recente decisão do Supremo Tribunal Federal (STF). — A Associação Brasileira dos Terminais de Contêineres (Abratec), representante legítima dos terminais portuários de contêineres no Brasil, vem a público posicionar-se diante da recente e acertada decisão proferida pelo ministro Dias Toffoli, do Supremo Tribunal […]
Segurança jurídica, simetria regulatória e diálogo Read More »